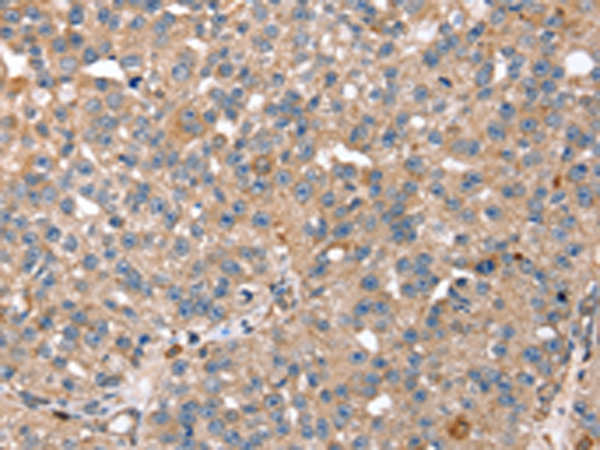
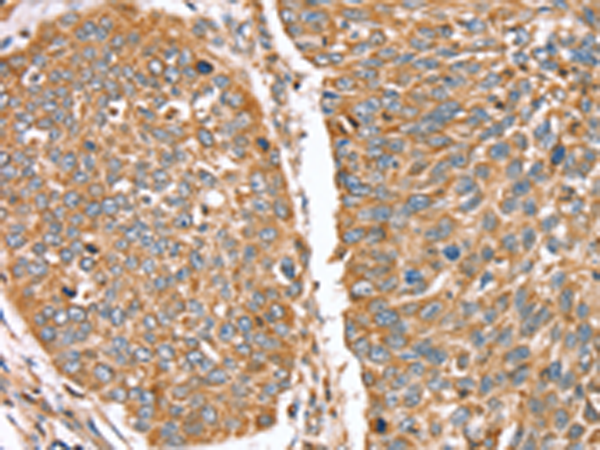

-
分类: 科研抗体货号: P08713别名: GRAIL应用: IHC反应种属: Human, Mouse
-
分类: 科研抗体货号: P08692别名: RGP4; SCZD9应用: IHC反应种属: Human, Mouse, Rat
-
分类: 科研抗体货号: P08701别名: RAI; RNH应用: WB,IHC反应种属: Human
-
分类: 科研抗体货号: P08712别名: ARA54; HFB30; TRIAD2; HRIHFB2038应用: WB,IHC反应种属: Human, Mouse
-
分类: 科研抗体货号: P08691别名: MST092; MST106; MST129; MSTP032; MSTP092; MSTP106; MSTP129应用: IHC反应种属: Human, Mouse, Rat
-
分类: 科研抗体货号: P08700别名: RNASE6PL; bA514O12.3应用: IHC反应种属: Human
-
分类: 科研抗体货号: P08711别名: BRE1B; RBP95; STARING应用: WB,IHC反应种属: Human, Mouse, Rat
-
分类: 科研抗体货号: P08690别名: CARP2; FRING; CARP-2; RNF189; RNF34L; RIFIFYLIN应用: IHC反应种属: Human, Mouse, Rat
-
分类: 科研抗体货号: P08726别名: GTR2; RAGC; TIB929应用: WB反应种属: Human, Mouse
-
分类: 科研抗体货号: P08710别名: CGI-123; SID1669应用: IHC反应种属: Human, Mouse

鄂公网安备42018502007531号
鄂公网安备42018502007531号

